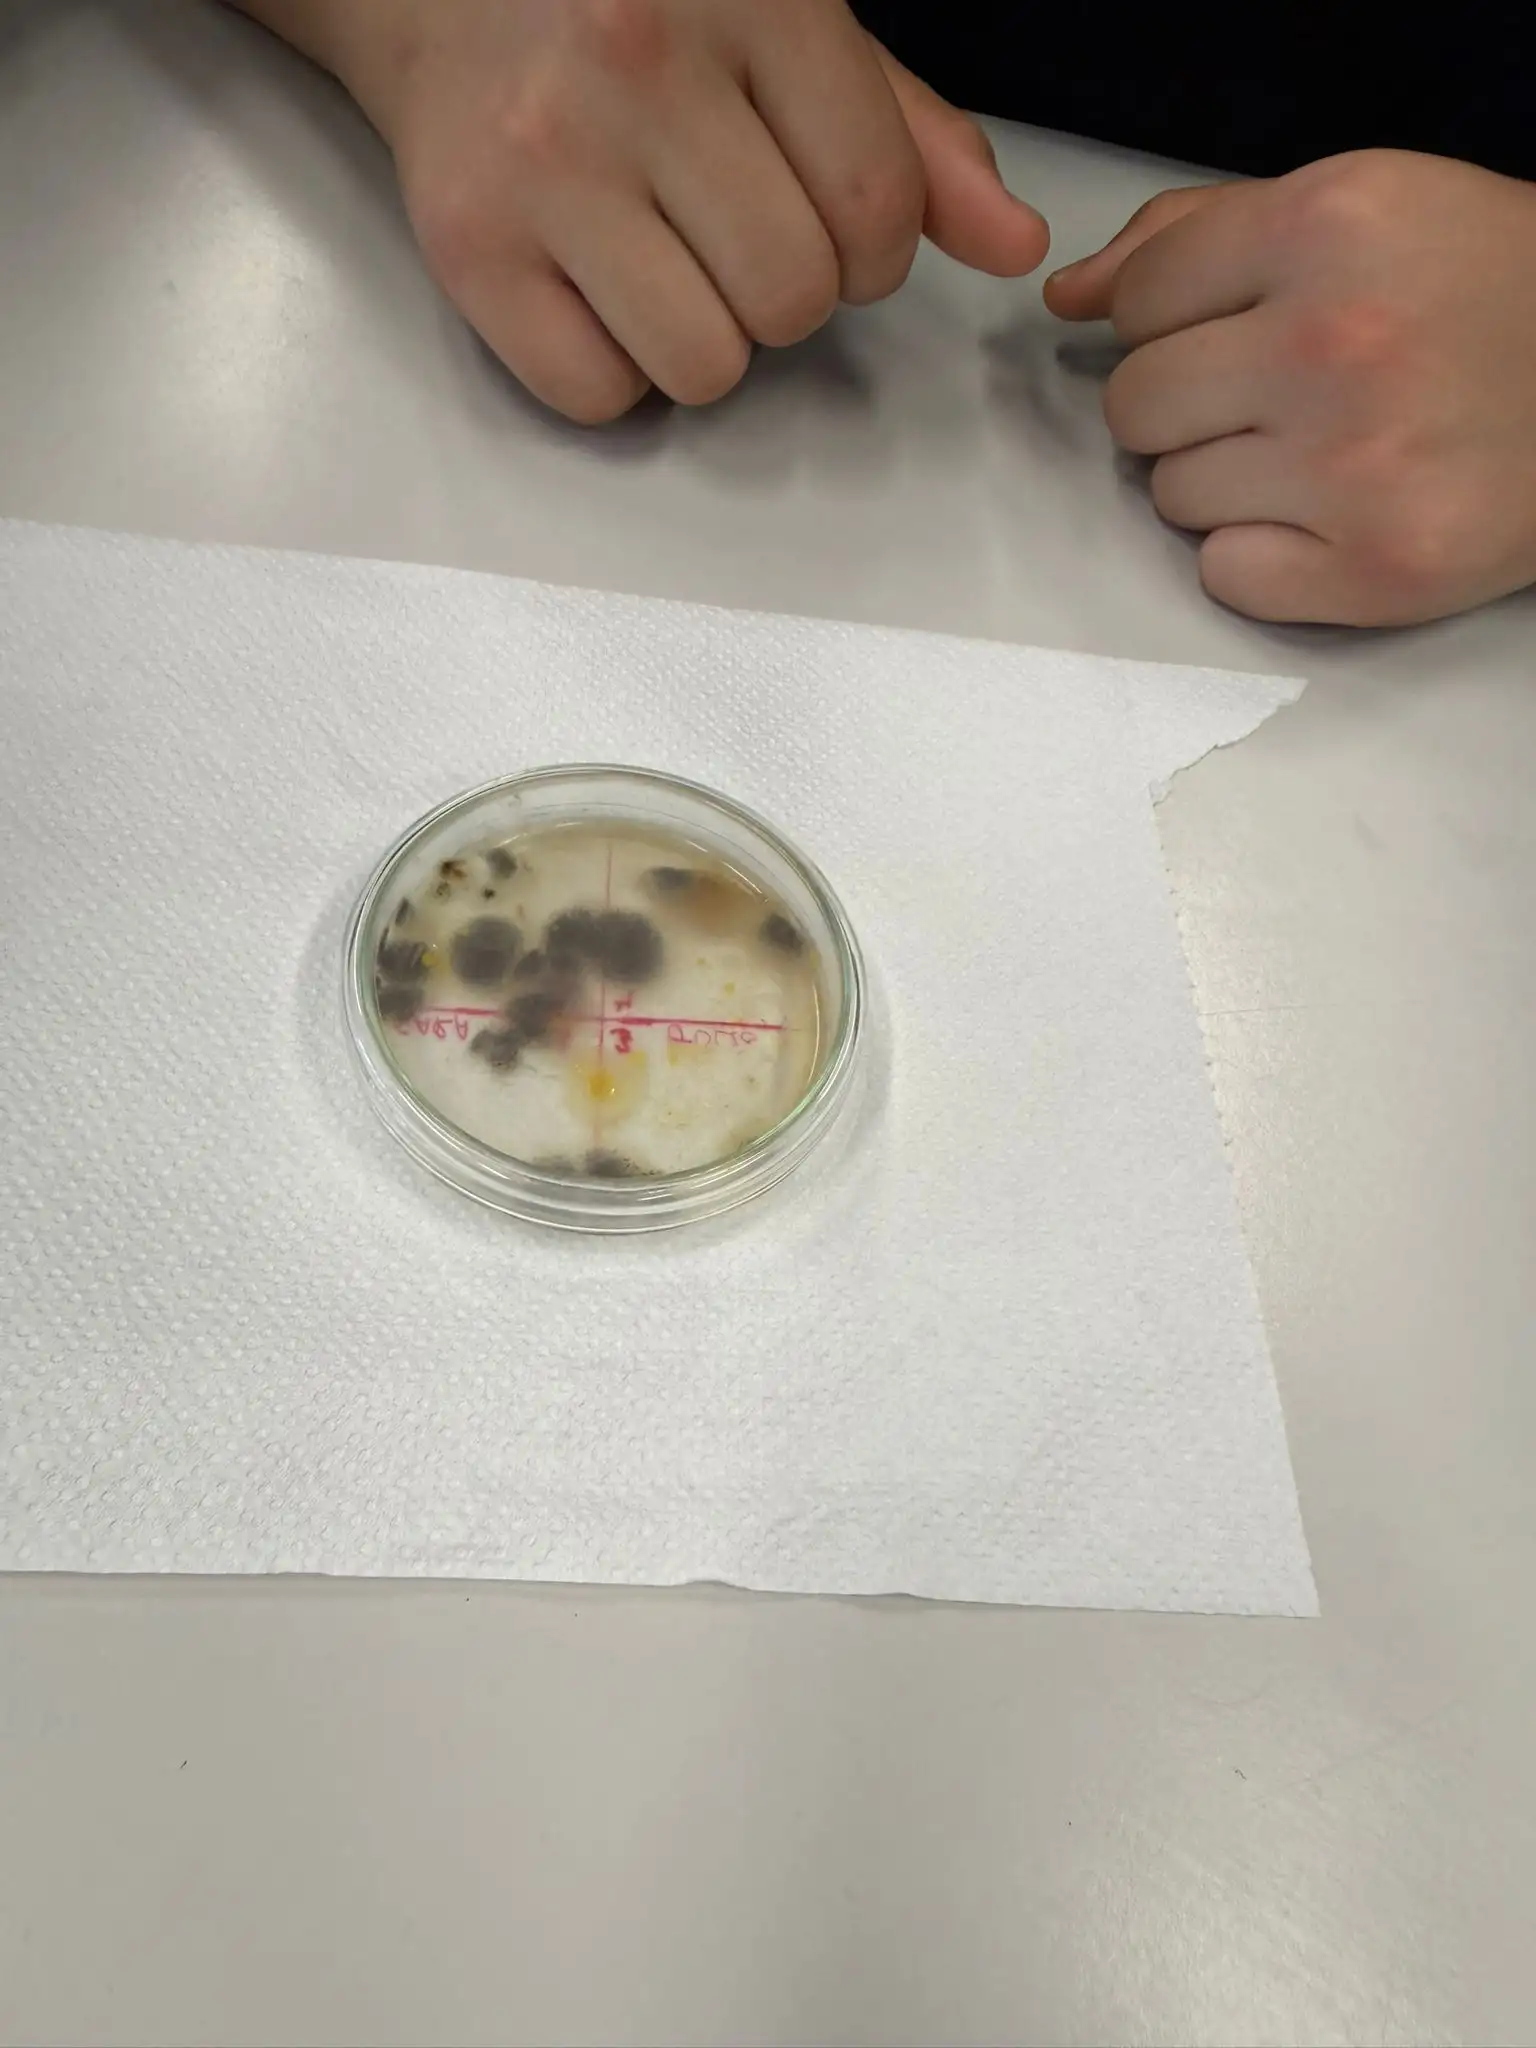

ACTIVITATS MARÇ 2026
03/03/26
En el entorno de nuestro patio Pigmalió, hemos vivido una experiencia única donde la palabra, el sentimiento y la tradición se han dar la mano. La actividad se centró en tres ejes que han marcado nuestra historia reciente y nuestra sensibilidad: la fuerza de la naturaleza (la DANA), el deseo de Paz y el recuerdo de la pandemia.
El alumnado se convirtió en poetas por un día, transformando sus vivencias y miedos en arte a través de versos y rimas, se expresaron diferentes realidades:
La DANA: Palabras de solidaridad para los afectados y respeto por el poder del agua.
La Paz: Un grito unánime por la convivencia y el final de los conflictos mundiales.
La Pandemia: Una mirada al pasado para recordar el que aprendimos y como es de importante cuidarnos los unos a los otros.
Además, Como parte central de la parte manual y artística, el patio se llenó de actividad creativa, elaboramos centenares de bolitas de colores. Estas bolitas no eran simples trozos de papel; representaban los deseos y las oraciones de cada alumno/a. Todas ellas fueron destinadas a confeccionar el manto de la Virgen, que lucirá con orgullo en la falla del instituto.
Hoy, el Aula Oberta con el taller de ampliación de 3º de ESO, para profundizar en el conocimiento de los microorganismos, estudiamos los microorganismos que viven a la superficie de nuestra piel, principalmente bacterias y hongos. Para poder detectar su presencia, es decir, para verlos e identificarlos se tienen que hacer crecer hasta lograr una medida macroscópica en forma de manchas que corresponden a colonias de millones de individuos unicelulares. Estos microorganismos se tienen que hacer crecer en unas condiciones adecuadas, por lo cual usamos unos recipientes denominados placas de Petri, que son unas cajitas redondas de vidrio o plástico transparente con tapa. Además hay que añadir un medio de cultivo sobre el cual puedan alimentarse y reproducirse con los nutrientes necesarios y temperatura óptima. La primera parte de la práctica consiste a elaborar el medio de cultivo. El medio de cultivo se prepara echando un sobre de agar-agar que es una sustancia espesante o gelificante, en 250 cl de caldo de carne o pollo. Se remueve y se deja hervir unos minutos. Dejamos enfriar un poco y derramamos una pequeña cantidad de 5 ml en cada placa de Petri y se tapa rápidamente. En pocos minutos el caldo se enfría, y forma una estrecha película de gelatina sólida. Finalmente ponemos las placas de Pétreo a la nevera para evitar la contaminación
04/03/2026
El instituto se convierte hoy en un escenario de reivindicación histórica y democrática. En una iniciativa impulsada y organizada desde la Coordinación de Igualdad y el Punt Violeta, el centro acoge la compañía de teatro Teatrea, que pose en escena una obra fundamental sobre la figura de Clara Campoamor, la abogada y política que cambió el destino de las mujeres en el Estado español.
Para que el mensaje llego con claridad y se pueda mantener un diálogo fluido entre el escenario y la grada, la Coordinación de Igualdad diseña una jornada estructurada en dos sesiones consecutivas. De este modo, la totalidad del alumnado de 1º de Bachillerato asiste a la representación distribuido en dos turnos horarios diferentes. Esta planificación permite que los grupos disfruten de una experiencia más inmersiva y que la reflexión sobre el derecho al voto y la igualdad sea mucho más profunda y participativa.
Arriba del escenario, los actores de la compañía Teatrea recrean con una fuerza conmovedora los debates parlamentarios de 1931. El alumnado de Bachillerato presencia el coraje de una mujer que, prácticamente sola ante una cámara reticente, defensa el derecho universal al sufragio. La obra no solo narra hechos históricos, sino que conecta directamente con los valores que el Punt Violeta promueve diariamente en el centro: la justicia, la libertad y la igualdad de género como pilares innegociables de cualquier sociedad.
La elección de este formato teatral por parte de la Coordinación de Igualdad y el Punt Violeta responde a la voluntad de sacar la historia de los libros de texto y darle voz y rostro. Al ver las dificultades y los prejuicios que Campoamor tuvo que superar, nuestros estudiantes toman conciencia que los derechos civiles son una conquista colectiva que hay que conocer y proteger.
La atención y el silencio respetuoso que dominan la sala durante las representaciones confirman el éxito de esta propuesta. Con esta actividad, el instituto arrecia su compromiso con una educación crítica y comprometida, recordando a las nuevas generaciones que la voz de Clara Campoamor continúa siendo, hoy más que nunca, una lección de dignidad necesaria para construir el futuro.
- Por qué este espectáculo?
Campoamor ejerció un papel decisivo en la defensa del valor de la igualdad. Y lo hizo con indudable mérito, rodeada de enemigos a los cuales, a diferencia de sus imperturbables principios humanistas, se llevó el viento de la Historia.
- Ver a personas encima del escenario que, han aprendido a superar sus miedos.
- Es una manera de aprender la historia a través de la emoción y no solo del dato y la fecha.
- Entender que la política nos afecta de manera directa a todas y todos.
- Entender la relación entre sociedad, política y filosofía.
- La Historia olvida a menudo el papel de la mujer.
Poner en valor a Clara Campoamor como motor de inspiración para mujeres y hombres
06/03/26
Hoy ha sido un día muy completo!
El centro ha avanzado la celebración del Día Internacional de la Mujer (8M). A pesar de que la jornada ha sido marcada por el contexto de la huelga, el compromiso de la comunidad educativa ha permitido que las actividades organizadas por el Punt Violeta salieron adelante, convirtiendo lo centro en un espacio de reflexión y visibilidad femenina.
– Exposición de Ilustraciones Científicas
Una de las intervenciones visuales más potentes de la jornada ha sido la exposición de dibujos dedicada a Maria Sibylla Merian. Esta actividad, fruto de una colaboración interdisciplinaria entre el departamento de Biología y el alumnado del PAC, ha llenado una pared del centro de natura e historia. Los trabajos, coordinados por una profesora de Biología, no solo destacaron por su calidad artística, sino por su valor didáctico: recuperar la figura de una mujer que, ya en el siglo XVII, desafió las convenciones para acontecer una de las madres de la entomología moderna. El hecho que el alumnado del PAC fuera el responsable de la realización y el montaje subraya la importancia de hacer un feminismo inclusivo, donde todo el alumnado es protagonista del cambio.
Aquí podemos observar los dibujos ganadores de este año:
– Entrega de Premios del Concurso de Memes
El otro plato fuerte del día ha sido el desenlace del Concurso de Memes Feministas, una iniciativa del Punt Violeta para conectar con el lenguaje actual de los jóvenes. El alumnado voluntario del Punt Violeta tomó la iniciativa en el acto de entrega de premios, reconociendo la capacidad del alumnado ganador para utilizar el ingenio y el humor mordaz como herramienta de denuncia social. Los memes seleccionados destacaron por su originalidad en la hora de cuestionar estereotipos, poner en evidencia micromachismos cotidianos y reivindicar la igualdad real en las aulas y en la calle
Además, hoy, el Aula Obierta ha seguido con el estudio de los microorganismos. La segunda parte de la práctica que empezamos el día 3, consiste a sembrar o cultivar las bacterias en la placa de Petri. Primeramente, hay que hacer una línea con rotulador permanente en la parte inferior dividiéndola por la mitad y rotulándola con la letra A y B, e identificándola, poniendo nuestro nombre. A continuación abrimos la tapa y presionamos con el dedo en la zona A, tocando ligeramente la superficie de la gelatina y cerramos rápidamente para evitar contaminaciones. Después de lavarnos las manos con jabón repetimos la misma operación en la zona B. Finalmente introducimos la placa de Petri en la estufa a 37 °C durante 72 horas. (El medio de cultivo en placa se puede sustituir por pan de molde que metemos dentro de bolsas de plástico para incubar los microorganismos.) Los microbiólogos suelen trabajar en un entorno estéril alrededor de una llama de un mechero Bunsen que crea una corriente ascendente de aire caliente. También usan un asa de siembra para transferir microorganismos de una placa a otra, que consta de un mango que lleva un filamento que se puede esterilizar a la llama
Por último, hoy las cocinas del PAC se han llenado de un aroma de aquellas que evocan a Fallas, tradición y hogar. No ha sido un día cualquiera; nos hemos puesto el delantal para enfrentarnos a un reto de repostería clásica: buñuelos de aire. Esta receta, que parece pura magia por su ligereza, requiere paciencia, buena mano y, sobre todo, mucha ilusión.
La preparación ha empezado poniendo al fuego una olla con 250ml de agua, 60g de mantequilla y una pizca de sal (5g). Cuando la mezcla ha empezado a hervir, hemos abocado de golpe los 160g de harina tamizada, y hemos ido incorporando los 4 huevos uno a uno, asegurándonos que cada uno quedara muy integrado antes de añadir el siguiente, junto con un toque de levadura química para garantizar ese vaciado interior tan característico. Por último hemos trabajado la masa con la espátula con energía hasta que se ha desprendido de las paredes de la olla, formando una bola homogénea.
Una vez templada la masa, ha llegado el momento clave:
Con la masa reluciente y con la consistencia perfecta, hemos pasado a la acción junto a la sartén. Con el aceite de girasol muy caliente, hemos ido depositando pequeñas porciones de masa que se han ido hinchando y dorando hasta quedar bien hinchadas. Una vez fuera, y después de soltar el exceso de aceite sobre papel absorbente, el toque final ha sido la lluvia de azúcar que los ha dado el aspecto de fiesta. Tal y como es nuestro alumnado el rebozado en azúcar ha sido bastante considerable 😉
Cómo en toda buena cocina profesional, no hemos olvidado la parte técnica y de seguridad alimentaria analizando detenidamente los alérgenos presentes en nuestra elaboración:
Gluten (presente en la harina de trigo).
Lactosa (en la mantequilla).
Huevo (ingrediente fundamental para la estructura).
Es vital conocer estos componentes para garantizar que la gastronomía sea un espacio seguro e inclusivo para todo el mundo.
La jornada ha culminado con un momento de gran expectación: Hemos tenido el placer de invitar a cuatro docentes del Punt Violeta, que se estrenaban hoy como nuevas personas catadoras. Lejos de ser una simple degustación informal, se han tomado su responsabilidad con un rigor admirable.
Con la libreta en mano y los sentidos muy despiertos, han evaluado cada aspecto del buñuelo: desde el dorado exterior y la textura crujiente, hasta la ligereza interior y el equilibrio de la dulzura. Ha sido fascinante observar como analizaban cada bocado con tanta seriosidad y profesionalidad, ofreciéndonos un feedback detallado que nos ayuda a crecer como cociner@s. Ha sido, sin duda, una sesión donde hemos mezclado aprendizaje, trabajo en equipo y el placer de compartir un producto muy hecho con un tribunal de excepción.
10/03/26
Hoy, con motivo de la conmemoración del Día Internacional de la Mujer Trabajadora, nuestro alumnado de 2º ESO PAC ha protagonizado una jornada de convivencia y aprendizaje compartido con los más pequeños del CEIP Padre Manjón donde se han trabajado cuentos que rompen estereotipo.
La actividad central consistió en una lectura de álbumes ilustrados. El alumnado de secundaria se ha convertido en cuentacuentos transmitiendo mensajes de igualdad a través de títulos tan emblemáticos como:
– Las princesas también se echan pedos: Una divertida manera de desmitificar los roles de género tradicionales.
– Rosa Caramel: Un clásico imprescindible para reflexionar sobre la libertad y la ruptura de los cánones impuestos.
Estas lecturas no solo fomentaron el hábito lector, sino que sirvieron como la herramienta perfecta para introducir la importancia de la igualdad de género, una temática especialmente relevante durante este mes de marzo.
Después de los cuentos, el grupo ha visualizado el video «La igualdad explicada para pequeños». Esta pieza audiovisual de corta duración fue el punto de partida para un enriquecedor debate entre «mayores» y «pequeños». El más gratificante de la jornada ha sido observar como los dos grupos han aprendido los unos de los otros. Nuestro alumnado de la ESO ha demostrado una gran madurez y sensibilidad, mientras que los niños y niñas de primaria han aportado una visión fresca y sincera sobre el mundo en el cual quieren crecer
Mientras el patio grande del instituto vibraba con la energía, los gritos de ánimo y la competitividad de los campeonatos femeninos de deportes, el patio Pigmalió se convirtió en un refugio inesperado de paz y concentración.
La estampa era curiosa y significativa. La gran mayoría de nuestras alumnas se encontraban a las pistas, siendo las protagonistas de una jornada deportiva que reivindicaba su papel en el centro. Esta ausencia masiva de las chicas hizo que al Pigmalió fuéramos pocos asistentes, pero esa circunstancia, lejos de deslucir la mañana, creó una atmósfera íntima y acogedora, ideal para una actividad que requiere pausa: los juegos de mesa.
Fue, en definitiva, una mañana de contrastes: por un lado, el empoderamiento y el movimiento de las chicas en el deporte y, de otra, la resistencia de los forofos a los tableros que mantenían viva la llama del Pigmalió. Una jornada que nos enseñó que, a veces, ser pocos permite disfrutar de las cosas con una intensidad diferente, y que nuestro patio siempre tiene un espacio para cada manera de vivir el instituto.
12-13/03/26
La hora del patio se transforma hoy en un espacio de desconexión y aprendizaje lúdico. Conscientes de la presión académica que vive el alumnado durante esta semana el Punt Violeta organizan una actividad especial para oxigenar la mente y, a la vez, continuar formando en valores: una partida colectiva al juego Cli-Sex.
El objetivo principal de la jornada es ofrecer un respiro en medio del calendario de exámenes. El patio deja de ser solo un lugar de tráfico para convertirse en un punto de encuentro donde la risa y el juego ayudan a rebajar los niveles de ansiedad. La propuesta tiene una acogida excelente y son muchos los y las estudiantes que se acercan a la tabla del Punt Violeta para participar.
El Cli-Sex es un recurso pedagógico en formato de juego que permite abordar la salud sexual y afectiva de manera natural, rigurosa y sin tabúes. A través de preguntas y dinámicas de grupo, el alumnado:
– Desmonta mitos sobre la sexualidad.
– Aprende conceptos clave sobre el consentimiento y el respeto mutuo.
– Refuerza la autoestima y el conocimiento del propio cuerpo.
Esta iniciativa demuestra que la educación afectivosexual es una pieza clave para mejorar la convivencia en el centro. Al jugar al Cli-Sex, los y las jóvenes no solo «desconectan» de los libros, sino que «conectan» entre ellos en un entorno seguro, basado en la confianza y la libertad de expresión. La valoración del patio de hoy es inmejorable: el alumnado agradece estas pausas activas que permiten aprender cosas vitales mientras se vacía la mente de fórmulas y fechas. El Punt Violeta arrecia así su función como motor de bienestar e igualdad dentro de la vida cotidiana del instituto

13/03/26
Ahora que estamos cerca de Fallas, el taller de cocina del alumnado del PAC se convierte hoy en un auténtico laboratorio de repostería tradicional. El objetivo de la jornada está claro: dominar el arte de hacer churros caseros, una receta que parece sencilla pero que requiere una precisión casi matemática y mucha traza con el fuego.
La actividad empieza con el pesaje de los ingredientes, un paso fundamental puesto que la repostería es una disciplina extremadamente precisa donde cualquier pequeña variación altera el resultado final: se pesan 120g de harina, 250ml de agua y 20g de mantequilla.
Posteriormente se pone a calentar el agua con un pellizco de sal y la mantequilla. Cuando el conjunto está bien caliente, se aboca la harina previamente tamizada despacio y se remueve sin descanso hasta conseguir una masa consistente que se separa de las paredes del recipiente. Finalmente, con la ayuda de una manga pastelera, se van formando los churros sobre el aceite abundante y muy caliente. Una vez dorados, se pasan a un papel absorbente para retirar el exceso de aceite y se espolvorean con azúcar por encima.
El alumnado se divide en dos grupos de trabajo, pero la jornada se ve condicionada por un problema logístico que marca la diferencia en los resultados:
– El Equipo Negro: Consigue realizar todos los pasos correctamente. Su masa tiene la textura ideal y los churros salen buenísimos, con el punto justo de cocción y sabor.
– El Equipo Blanco: Sufre las consecuencias de una avería inesperada: la báscula se rompe en el momento más inoportuno. Como que la repostería no admite aproximaciones, la falta de precisión en el pesaje hace que la receta no salga bien. En el primer intento, la masa queda demasiado líquida y se les pega tanto a los dedos que se tiene que tirar. En el segundo intento, la masa acaba con demasiada harina y tampoco es apta para freír. Como consecuencia, el equipo no puede presentar ningún plato a la cata final.
Ante esta situación, queda patente la necesidad de comprar una báscula nueva para garantizar que los futuros talleres mantengan el rigor necesario.
Cómo en toda actividad alimentaria, se tiene mucho en cuenta la seguridad del alumnado, en esta receta identificamos los siguientes alérgenos:
Gluten: presente en la harina de trigo y lactosa: presente en la mantequilla.
A pesar de los contratiempos del equipo blanco, el profesorado que asiste a la cata queda muy satisfecho. Los churros del equipo negro están deliciosos y reciben una valoración muy alta. Esta sesión sirve para aprender que, en la cocina, el éxito depende tanto de la traza de los cocineros como del buen estado de las herramientas de medida.
20/03/26
Hoy en el Punt Violeta, se ha seguido jugando al Cli-sex y se han seguido cortando sillitas de cartulina azules y moradas. Como ya explicamos en febrero, que fue cuando empezaremos con esta iniciativa, el debate se centra en la baja representación femenina en las esferas de poder. Para materializar esta idea, el grupo decidió crear una gran instalación de «sillitas de cartón» que representan los gobiernos del mundo. Como ya explicamos, se estableció uno el código de colores: las sillas de color azul para países con líderes masculinos (presidentes o primeros ministros) y las de color morado para aquellos estados gobernados por mujeres. Por ahora seguimos recortando sillitas a la espera de tenerlas todas y pasar al montaje
24/03/26
La hora del patio de hoy tiene un ritmo diferente. En la zona Pigmalió, el espacio delimitado con sus mesas se convierte en el epicentro de una actividad creativa. El alumnado del programa no está solo por almuerzo o charlar; hoy las mesas están cubiertas de libros, libretas y hojas sueltas, donde todas las parejas se juntan con un objetivo claro: preparar los poemas para el próximo recital. Alrededor de las mesas, los tutores y tutoras guían sus tutorand@s en la elección de los textos trabajando la lectura comprensiva y la entonación. Los más mayores explican el significado de las metáforas a los más pequeños, mientras estos ensayan como proyectar la voz para perder el miedo escénico
Después de este ensayo intenso al patio, la acción se traslada al recital en el Salón de actos, organizado por el departamento de Clásicas con motivo del Día Mundial de la Poesía. Varias parejas pigmalioneres dan el paso y suben al escenario para participar en el acto. Es un momento de gran orgullo ver como el trabajo hecho previamente a las tablas del patio da sus frutos. Tutor y tutorad@ comparten el atril, recitando versos que conectan el mundo clásico con la sensibilidad actual. Esta colaboración entre el programa Pigmalió y el departamento de Clásicas demuestra que la poesía es un puente perfecto para la unión del centro y el crecimiento personal del alumnado.
Hoy, el Aula Oberta con los/las compañeros y compañeras de 3º de ESO, han hecho la tercera parte de la práctica sobre el estudio de los microorganismos, que consiste a hacer un análisis de los resultados. Previamente, cada alumno planteó su hipótesis de en qué parte de la placa encontrará más microorganismos, para contrastarla posteriormente (confirmación o rechazo de la hipótesis).
El análisis que hemos hecho es cuantitativo: la parte de la placa donde aparecen una cantidad más elevada de manchas o colonias corresponde al dedo de las manos sucias. En algunos casos se puede distinguir las colonias de hongos o mohos de las colonias de bacterias porque la mancha muestra un vello como de algodón en rama que corresponde a las hifas del micelio vegetativo.
Esta práctica nos enseña la importancia de la limpieza corporal y especialmente de las manos para evitar la transmisión de enfermedades infecciosas.
En la segunda parte de la clase, para continuar la investigación de la anatomía humana aprovechamos la disección de un riñón para estudiar la estructura y funcionamiento del aparato excretor urinario. El riñón es un órgano en forma de judía la función del cual es formar y excretar la orina que contiene las sustancias de deshecho del metabolismo celular transportadas por la sangre. En este caso usamos un riñón de cerdo de unos 10-12 cm, muy parecido al nuestro que previamente hemos cortado de forma longitudinal dejándolo abierto como un libro. La parte cóncava o hileo presenta un surco de entrada de las arterias y venas renales así como el uréter, conducto de expulsión de la orina hacia la vejiga. Desgraciadamente, no conserva la glándula suprarrenal productora de adrenalina pero, podemos distinguir externamente la cápsula que recubre su superficie, que es de color marrón cobrizo. Internamente, diferenciamos tres partes de fuera para adentro: corteza, médula y pelvis renal.
El que podemos ver a simple vista es la parte externa o corteza que tiene una superficie uniforme y rodea la médula donde se pueden observar unas estructuras triangulares, entre 10 y 15, de un rojo intenso, son las pirámides de Malpighi, que acaban en una papila que conduce la orina hacia los calices, tejido de color blanquecino, que a manera de bolsas la recogen en la pelvis y lo abocan seguidamente por el uréter.
La nefrona es la unidad funcional del riñón. Cada riñón presenta casi un millón de nefronas microscópicas formadas cada una por un conducto sinuoso de unos 20-40 mm de longitud muy vascularizado que consta de las siguientes partes: glomérulo de Malpighi, cápsula de Bowman, túbulo contorneado proximal, asa de Henle, túbulo contorneado distal y túbulo colector.
De todas estas estructuras microscópicas solo el asa de Henle y los túbulos colectores se encuentran en la zona medular, el resto en la corteza. Si abocamos unas gotas de agua oxigenada sobre la zona medular y secamos con papel podemos visualizar en las pirámides de Malpighi unos filamentos paralelos blancos que corresponden principalmente a los túbulos colectores.
Pero ¿Como se forma la orina? La sangre rica en oxígeno, pero también con sustancias de deshecho llega con presión por la arteria renal que se ramifica en arteriolas y capilares arteriales hasta llegar a cada glomérulo de la corteza. Como que la pared de cada capilar presenta solo una capa de células (endotelio) y la presión es tan grande, se filtra la mayor parte de la sangre a la cápsula de Bowman (agua, glucosa, sales minerales, vitaminas, ácido úrico, urea y medicamentos) excepto células sanguíneas y proteínas grandes. De este primero filtrado se reabsorben a los capilares venosos la mayor parte de las sustancias útiles que pasan por el asa de Henle y túbulos contorneados, excretandose en la orina definitiva sustancias de deshecho en el túbulo colector. Estas estructuras las observamos finalmente en una preparación permanente de un corte histológico de riñón de ratón al microscopio. Se diferencian muy claramente los glomérulos de Malpighi formados por una madeja de capilares arteriales dejando un espacio vacío que rodea la cápsula de Bowman, entre ellos se observan círculos de diferentes secciones que corresponden a los túbulos contorneados.
25/03/26
Hoy el alumnado que forman parte del Punt Violeta cambiamos las aulas por las calles de València en una jornada intensa dedicada a la cultura feminista y a la memoria histórica
Empezamos la mañana en la Biblioteca de la Mujer: Mientras hacemos la visita guiada, descubrimos que este es un espacio clave para visibilizar las autoras que la historia a menudo ha olvidado. El momento más emocionante? Cuando nos hacemos el carnet de la biblioteca. Ya lo tenemos en la mano! Ahora ya no tenemos excusas por no venir a buscar esas lecturas que nos ayudan a entender mejor el mundo con gafas moradas.

En la segunda parada hemos ido al MuVIM
Con el carnet en el bolsillo, nos desplazamos hacia el MuVIM. Allí nos espera una mirada al pasado a través del objetivo de Luis Vidal Corella. Su exposición fotográfica sobre la vida en el franquismo nos deja sin palabras, fijándonos en la situación de la mujer durante aquellos años:
Vemos fotografías que retratan una cotidianidad marcada por la precariedad.
Observamos como las mujeres estaban recluidas en el ámbito doméstico o en trabajos muy duros.
Analizamos la pérdida de libertades y la fuerte influencia de la censura y la religión en la imagen femenina.
Es sobrecogedor ver como era el día a día de nuestras bisabuelas y yayas. Nos hace valorar mucho más todo el que hemos conseguido, pero también nos recuerda que los derechos no se pueden dar nunca por sentados. Volvemos hacia el instituto con muchas ideas en la mente y ganas de compartir todo lo que hemos aprendido. Visitar estos espacios nos hace sentir que el Punt Violeta no es solo una mesa en el patio, sino una conexión viva con la historia y la cultura de nuestro territorio.
26/03/26
Gracias a nuestro PIIE, vamos a renovar la imagen del patio Pigmalió, y en la primera estación para hacerlo, el alumnado PAC ha ayudado muchísimo! Con las brochas en la mano y mucha motivación, el grupo se ha encargado de transformar el entorno de trabajo de las parejas pigmalioneres, dándole una identidad visual clara y potente.
La actividad se centra a pintar las vallas de madera que delimitan la zona Pigmalió. El alumnado se organiza por turnos, protegiendo el suelo y aplicando una capa de pintura de un rojo vivo. Este color no se ha elegido al azar: representa la energía y la calidez de un proyecto basado en el acompañamiento y la amistad. Mientras unos extienden la pintura con el rodillo por las zonas anchas, otras repasan con cuidado los rincones de la madera con pinceles más finos, demostrando una gran destreza y paciencia.
El resultado es espectacular. Lo que antes era una valla sencilla ahora es un espacio acogedor y muy definido que invita a la lectura y a la conversación. Con este trabajo, el alumnado del PAC no solo mejora la estética del centro, sino que se siente protagonista de la creación de un espacio de convivencia necesario para todo el instituto. Ahora solo queda el montaje!
27/03/26
Después de tantas semanas de reuniones, campañas de sensibilización y trabajo colectivo, hoy nos merecemos un respiro! El curso avanza y, antes de marchar de vacaciones, el Punt Violeta se transforma por un día: cambiamos los carteles y las planificaciones por una buena picaeta de fin de trimestre.
Hoy el ambiente en el instituto es diferente. Nos hemos reunido todo el alumnado colaborador del punto para hacer balance, pero de la manera que más nos gusta: alrededor de una mesa llena de cosas buenas. Hay de todo: papas, olivas, frutos secos, algunas cocas y bebidas frescas para combatir el calor o el cansancio acumulado.
Hagamos piña: Es el momento perfecto para charlar con compañeros y compañeras de diferentes cursos con quienes normalmente no coincidimos tanto.
Reímos y desconectamos: Entre bocado y bocado, recordamos anécdotas de las últimas actividades y nos relajamos después de los exámenes.
Proyectamos el futuro: A pesar de que estamos de celebración, ya van saliendo ideas para el próximo trimestre. La energía no para!
Con la panza llena y las pilas cargadas, nos despedimos hasta la vuelta de las vacaciones. Nos vemos con más ganas de continuar haciendo del instituto un espacio libre de machismo y pleno de respeto.Buen final de trimestre y a disfrutar del descanso! Nos vemos a la vuelta! 💜
Hoy el Aula Oberta ha realizado una práctica muy especial. Como actividad de final del segundo trimestre y enmarcada dentro de la jornada de Talleres ODS, nuestro departamento de Biología y Geología propone un taller de alimentación saludable que consiste en la elaboración de queso fresco (requesón) así como, la comprensión de los procesos fisicoquímicos que lo hacen posible.
Para elaborar el queso, calentamos un litro de leche en un cazo, preferiblemente leche entera, puesto que la grasa facilita el proceso. Controlamos la temperatura con un termómetro hasta 70 °C. (No tiene que hervir). Apagamos el fuego y añadimos el zumo de una limón mientras removemos con una cuchara (de madera, preferiblemente, porque los metales reaccionan químicamente con los ácidos, como el limón, modificando las propiedades organolépticas, como el gusto) En cuestión de segundos observamos como la leche empieza a cortarse, es decir, se forman grumos blancos, el cuajo, que flotan entre un líquido acuoso y amarillento, el suero. La leche es una mezcla homogénea de diferentes sustancias dispersas o disueltas: glúcidos, lípidos, proteínas, etc. La temperatura elevada de 70 °C y un medio ácido proporcionado por el zumo de lima han modificado las propiedades fisicoquímicas de la leche, y las proteínas solubles se han desnaturalizado, precipitando, formando el cuajo, una red proteica con grasas, insoluble que constituye el queso. Para separar el suero del cuajo o queso usamos un trapo o una tela porosa de algodón. Con unos guantes puestos hay que girar la tela presionando sin quemarse para eliminar el máximo de líquido (suero) y darle forma al cuajo o queso. Se deja enfriar y ya se puede comer sol o con una tostada con mermelada, miel, etc. Este queso fresco es la base por la elaboración otros quesos madurados. Se pueden condimentar al gusto, con sal, especies, frutos secos, etc. Este queso es muy perecedero, y hay que comerlo como mucho en tres días, puesto que solo lleva los conservantes y aditivos de la leche, y limón, por lo cual también es más saludable.
Por último, pero no menos importante, desde las 9:00 de la mañana, el alumnado del PAC (Programa de Aula Compartida) ha tomado el mando de los fogones para preparar una de las citas más esperadas del trimestre: una cata inclusiva de empanadillas de Pascua destinado al alumnado de 1º de Bachillerato de Ciencias.
El proceso empieza con el primer gran reto, que es la elaboración de una masa casera perfecta.
Con mucho cuidado, se calientan 200 ml de agua hasta que llega en su punto de temperatura idóneo. Es en ese momento cuando se añaden 50 g de mantequilla, viendo como se deshace lentamente hasta integrarse completamente. Posteriormente incorporan 400 g de harina, y se mezcla todo con energía y constancia hasta que la mezcla se transforma en una masa elástica, suave y, sobre todo, que ya no se pega en los dedos. Después de dejarla reposar unos minutos, lo extienden con el rodillo sobre el banco y, con la ayuda de un molde redondo, van cortando las piezas que servirán de base para las empanadillas.
Mientras unos acaban de dar forma a la masa, otros se dedican a la elaboración de los dos rellenos protagonistas de la jornada. Por un lado, se cocina una sabrosa salsa boloñesa con carne de ternera picada de primera calidad; por otro lado, se prepara el relleno más clásico de nuestra tierra: una mezcla armónica de salsa de tomate, atún y huevo duro muy picado.
Una vez rellenas als empanadillas y cerradas con cuidado, se pintan con huevo batido para darles ese acabado brillando tan característico. El horno, ya precalentado a 180 °C, las recibe hasta que adquieren un color dorado que indica que ya están listas.
Un punto clave de esta actividad ha sido trabajar la receta y la seguridad y la gestión de las alergias. Durante todo el proceso, el alumnado ha estado muy consciente de los ingredientes utilizados: la harina aporta gluten, la mantequilla contiene lactosa, el tomate contiene fructosa y el huevo es un alérgeno directo. Se ha tenido un cuidado extremo para evitar contaminaciones cruzadas, asegurando que la cata sea una experiencia segura para todo el mundo y aprendiendo a leer con detenimiento las etiquetas de los productos.
En la hora del patio, la actividad se traslada al exterior. Bajo una carpa montada expresamente para la ocasión, se instalan dos mesas donde se disponen las bandejas con las empanadillas. Los carteles con el título «Cata de Pascua» y las recetas detalladas ayudan a dar un aire profesional al acontecimiento.
El alumnado de 1º de Bachillerato de Ciencias, acompañado del profesor de castellano Miguel Ruiz García, acude a la cita con curiosidad. Es un momento de encuentro precioso donde los roles se desdibujan: los cocineros del PAC explican el procedimiento técnico y los ingredientes a sus compañeros de Bachillerato.
El veredicto de la cata es muy positivo. Las fichas de puntuación muestran un 5 sobre 5 en cuanto a la masa; todo el mundo coincide que la textura es excepcional y el sabor delicioso. Cómo en toda buena crítica gastronómica, también hay espacio para la mejora: algunos alumnos comentan que para la próxima ocasión les gustaría encontrar un poquito más de relleno en el interior de la empanadilla.
Esta cata inclusiva acaba con sonrisas y la panza llena, pero sobre todo con la satisfacción de haber compartido un espacio común donde el PAC y el Bachillerato se han unido gracias al trabajo bien hecho y a la tradición de la Pascua.